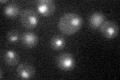
YGR252W

View description
Histone acetyltransferase, acetylates N-terminal lysines on histones H2B and H3; catalytic subunit of the ADA and SAGA histone acetyltransferase complexes; founding member of the Gcn5p-related N-acetyltransferase superfamily
Localization:
Intensity:
Fold change:
Significance:
-
C’ GFP library in SD
nucleus28.31 -
N' NOP1pr-GFP in SD

nucleus79.6823 -
N' TEF2pr-mCherry in SD

nucleus68.1316 -
N' NATIVEpr-GFP in SD

nucleus22.8141 -
N' TEF2pr-VC and Cyto-VN in SD

nucleus35.9833 -
C’ GFP library in SD+DTT

nucleus25.820.91No -
C’ GFP library in SD+H2O2

nucleus27.590.97No -
C’ GFP library in Starvation Media

nucleus25.560.9No -
C’ GFP library on the background of Pup2-DaMP

nucleus -
C’ GFP library on the background of CCT mutant

nucleus32.26941.13945No
